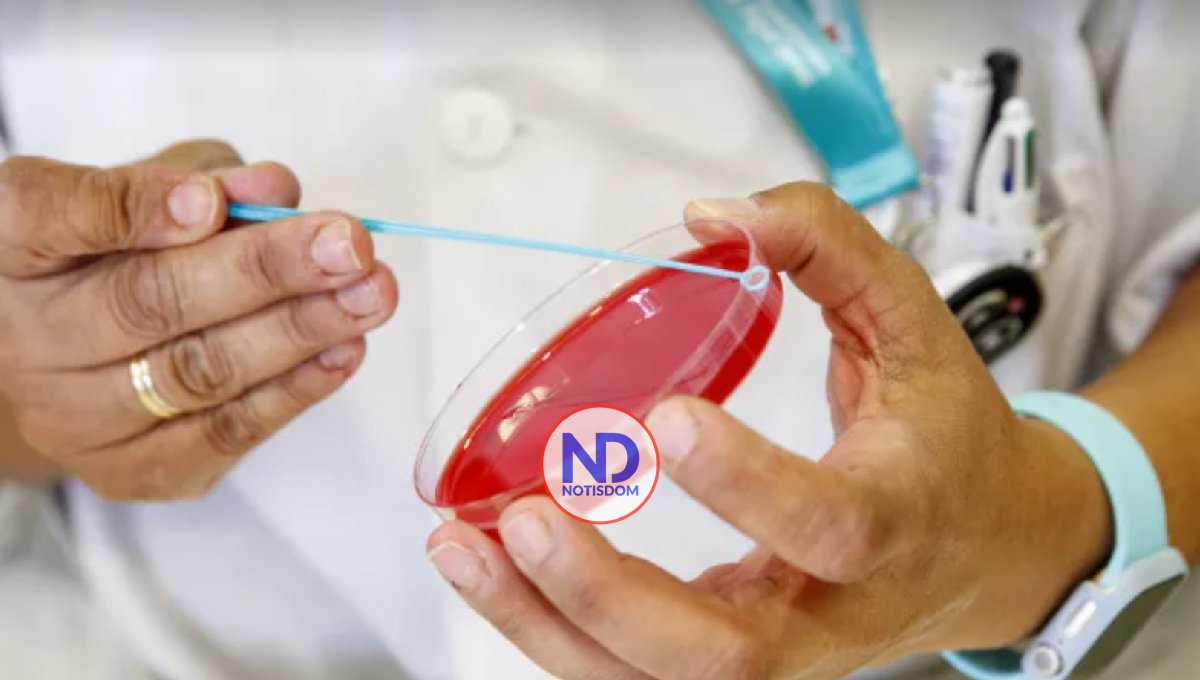
Descubren cómo el virus SARS-CoV-2 se comunica con las células humanas

Descubren cómo el virus SARS-CoV-2 se comunica con las células humanas
ESPAÑA.- Una investigación internacional ha descubierto cómo se comunica con las células humanas el coronavirus SARS-CoV-2 y ha encontrado más de 200 interacciones de proteína a proteína entre el virus y las células que toca.
El estudio, que publica la revista «Nature Biotechnology» y en la que ha participado el Instituto de Investigación Biomédica (IRB) de Barcelona, se planteó responder a estas tres preguntas: ¿Cuáles son exactamente las interacciones moleculares entre el virus causante de la covid-19 y su huésped humano? ¿Cómo pueden nuestras diferencias genéticas causar diferentes cursos de la enfermedad? ¿Y cómo difieren las variantes del virus, aún emergentes, en sus interacciones con el huésped?.
La investigación la ha llevado a cabo un consorcio internacional, dirigido Pascal Falter-Braun, director del Instituto Helmholtz de Biología de Redes de Múnich (Alemania), e incluyó equipos de Canadá, Estados Unidos, Francia, España y Bélgica.
Científicos del laboratorio de Bioinformática Estructural y Biología de Redes del IRB de Barcelona, dirigido por Patrick Aloy, han contribuido analizando la red de interacciones entre el virus y las células humanas.
Ente otras cosas, los científicos han descubierto que muchas proteínas virales muestran una preferencia de unión a dominios estructurales específicos presentes en varias proteínas humanas.
«Comprender mejor las interacciones del virus con nuestras células es clave para evitar esas interacciones y, así, la infección. De hecho, el consorcio ya ha probado con éxito algunos compuestos con este fin. Estudios posteriores evaluarán cómo la variabilidad genética de los huéspedes humanos afecta a estas interacciones», avanzó Aloy.
A diferencia de los anteriores estudios sobre asociaciones proteínicas, ahora han podido identificar con precisión los contactos proteínicos directos entre el virus y el huésped.
Al examinar de cerca este conjunto de interacciones proteicas directas (o «contactoma»), el equipo encontró cadenas de conexiones entre las proteínas víricas y los genes humanos relevantes para la infección.
Por ejemplo, pudieron rastrear conexiones entre ciertas proteínas del SARS-CoV-2 y proteínas humanas codificadas por los genes que se han relacionado con una mayor probabilidad de covid-19 grave en otros estudios.
También encontraron conexiones entre las proteínas virales y los genes implicados, por ejemplo, en trastornos metabólicos como la obesidad y la diabetes.
Ya se sabía que las diferencias genéticas en los humanos desempeñan un papel importante en el curso y la gravedad de una infección por covid-19, pero ahora, gracias a identificar los puntos de contacto moleculares, es posible examinar los mecanismos subyacentes, según los investigadores.
Entre los primeros datos se encuentra la demostración de que importantes vías de señalización inflamatoria son activadas directamente por el virus, unos contactos que podrían explicar la exagerada reacción inflamatoria que desempeña un papel importante en los casos graves de covid-19.
También han visto que los contactos proteína-proteína no solo apuntan a impactos en la función de las células humanas y el sistema inmunitario humano, sino también en la función del SARS-CoV-2, incluida la velocidad de replicación del virus.
Tras ver la influencia mutua de las conexiones proteína-proteína, los investigadores ha elaborado un mapa sistemático de contactos que apunta a muchas posibles dianas farmacológicas.
Los científicos han podido confirmar, por ejemplo, que la proteína humana USP25 es reclutada para ayudar a ciertos procesos virales y que su inhibición reduce significativamente la multiplicación del virus.
Han usado la tecnología más avanzada para trazar el mapa de contactos que, según explican, fue como resolver un enorme rompecabezas.
Los investigadores examinaron y visualizaron sistemáticamente las interacciones de unas 30 proteínas víricas, cada una de ellas con unas 17.500 proteínas humanas interrogando a 450.000 pares de proteínas, una tarea ingente que sólo pudieron llevar a cabo con la ayuda de la robótica, el análisis computacional y métodos de biología molecular y de inteligencia artificial.
Creen que el mapa del contactoma servirá de plataforma para que la comunidad científica estudie con más detalle las interacciones individuales y comprenda su impacto en los mecanismos moleculares y la progresión clínica, y así descubra puntos de partida para nuevas estrategias terapéuticas.
